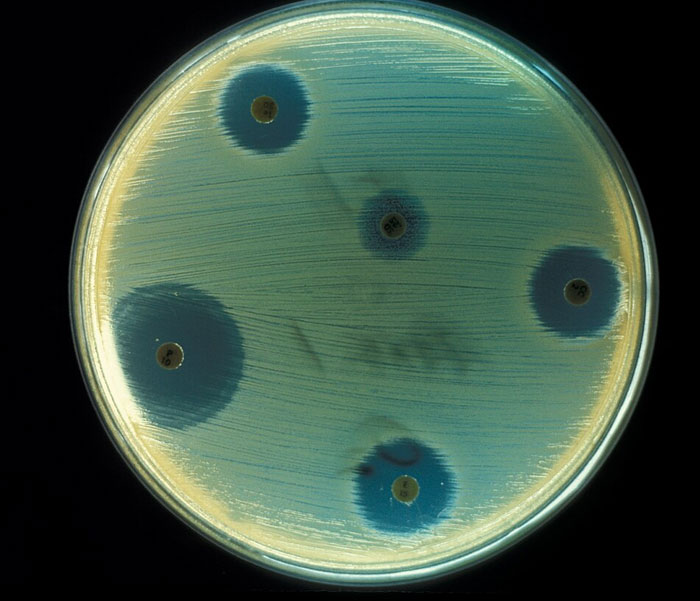
Petri dish showing antibiotic resistance zones as a weird and iconic bruh moment in history science experiment.

People tend to say "bruh" when something absurd happens. But would you say there's a historical moment that deserves such a description or reaction? Granted, many absurd things have happened throughout history (and we don't need to look back many years to find them).
There have been fights between cities because of buckets, people who survived both the Hiroshima and Nagasaki disasters, and a secret army masquerading as a giant wooden horse. Pretty crazy stuff when you think about it, isn't it?
One netizen collected all these incredible moments in one place when they asked: "What historical event can accurately be referred to as a 'bruh moment?'" Are you curious to find out, too? Scroll down and see the most interesting answers for yourself!
This post may include affiliate links.

 The Australian emu war.
The Australian emu war.
Deliberately attempting to exterminate a whole species because they are problematic is always a bad idea.
They didn't try to exterminate the emus though, they wanted to reduce their numbers to protect harvests. Mao in China on the other hand tried that with sparrows
Load More Replies...That’s an ostrich. Which is probably how the war started. You see, one day an ostrich walks into this Australian bar… Oh we wish this was just a joke… Anyway this ostrich walks into a bar. A visiting American, that happened to just arrived that morning for his first ever visit to Australia - Qantas flight 12, if you were wondering. It is one of this huge Airbus 380s. Double decks in it. Those monsters seat 485 people! Well Tony, our American, and his girlfriend, Laura flew in economy, seats 61G and 61H, in case you were that curious. They saved a lot for this trip but not enough to afford business class. Since Tony is manager at a Panera Bread restaurant. They pay their managers decent. But not at business class levels. (Oops, have to go to part 2)
Part 2, — Laura used to make good tips at the Hooter’s in Tucson, Arizona where she worked. If you was have met Laura you would right away understand how well she did. But that Hooter’s closed two years ago. Changing times, I guess. Tony and Laura are in this legendary Emu bar that they had seen on National Geographic and wanted to make it their first stop. When said ostrich walked in. You know, no one seems to have recorded that ostrich’s name. And Tony, being the friendly American he was. Invited the ostrich to his and Laura’s table. “Barkeep, how about a beer for my new emu friend here.” Well, Tony was a little weak on his knowledge of large flightless birds. Someday I will have to tell you about Tony’s Cassowary kerfuffle. But not here. But Laura knew her birds because her parents took time to take her and her sister to the zoo. So Laura just hung her head and shook her head slightly.
Part 2.2 they really need to make these fields longer — Now the bartender did not notice the ostrich at first. He was too busy checking out Laura. Remember the bit about the Tucson Hooters and she did well making tips? ( Now you can go to part 3)
Part Trois, Sh*t Goes Down! — So the bartender finally notices the mislabeled bird is an ostrich. “Hey, we don’t serve their kind here!” Tony, being a naive peacemaker, said it was ok his friend here is an emu. Well that not only made the bar keeper mad. But the ostrich too. I mean what the f**k, the ostrich thought. But he did not censor that word in his now angry head, does this guy mean confusing him with some short unworthy emu. The bartender punched Tony in his right eye. Knocking his head to the left. If someone had had their camera out then and set on slo-mo. It would have looked so awesome to see Tony’s cheeks vibrating and flapping from the punch. Two streams of spit knocked from his mouth flying off to the side. The ostrich at the same time went to hit Tony in the head with his beak. But where Tony’s head was a tenth of a second before. Was now where the barkeeper’s arm is. (You know the drill. Go to part IV)
Part IV, The Flock Strikes Back — The ostrich hit the bartender’s arm with incredible strength. An ostrich can crack a windshield with its beak. That is how hard they can hit. I know, I had one do that to my car at a safari park. And I had my kids in the car! So now the bartender has a lot of pain and is really mad as hell and he punches at the mislabeled ostrich. Well everyone in the bar saw this. Most wanted to jump in the fight with the bartender. About a third of those there were uncomfortable with how the bartender had said, “..their kind..”. It brings up images of unfortunate race relations of the past. But hell, their Australians. So they are in for the fight no matter what. Now with the emus there. About half saw that a POS ostrich had come in their bar. But the other half did not see him but heard, “..my emu friend here.” So they think that someone is attacking a brother emu. (Yep, there’s a part 5)
 When 100 russian soldiers who barely survived poison gas attack(and were close to d**ng anyway) charged against 7000 german soldiers in WW1. The russians were so abnormal mutilated by the gas that the germans thought they were attacked by zombies. Spoiler alert: the russians won.
When 100 russian soldiers who barely survived poison gas attack(and were close to d**ng anyway) charged against 7000 german soldiers in WW1. The russians were so abnormal mutilated by the gas that the germans thought they were attacked by zombies. Spoiler alert: the russians won.
 When Teddy Roosevelt was s**t before he was supposed to give a speech.
When Teddy Roosevelt was s**t before he was supposed to give a speech.
The bullet was slowed down by the folded up 50-page speech, so it did not k**l him. The bullet was inside him and he was bleeding, but he still went on and have the speech, which was 84 minutes long.
He started it off with "It takes more than that to k**l a Bull Moose" and showed the crowd the speech with the hole in it. That's a pretty "bruh moment" and humiliating to your would-be assassin.
 In WW1 when everyone stopped fighting on Christmas and came out of the trenches and drank together in no man's land.
In WW1 when everyone stopped fighting on Christmas and came out of the trenches and drank together in no man's land.
That's the wrong helmet⏫ (looks like an American one??) This is WW1 helmet ---> s-l1600-68...c299b8.jpg 
 When the Germans during WW1 disguised one of their ships as the British's HMS Carmania so they could wreck some ships without being recognised as a German ship. As the German ship went into the open seas, it met the real HMS Carmania which then immediately sank the German's disguise. Bruh.
When the Germans during WW1 disguised one of their ships as the British's HMS Carmania so they could wreck some ships without being recognised as a German ship. As the German ship went into the open seas, it met the real HMS Carmania which then immediately sank the German's disguise. Bruh.
The Carmania was a British armed merchant. The Cap Trafalgar was german raider. The Cap Trafalgar was disguised as the Carmania to attack allied shipping, and met the OG Carmania, shelling the hell out of it and being shelled in return. The Kronprinz Wilhelm, another German armed liner, came to the scene, but decided not to get involved mistaking the sinking german ship for the actual Carmania, and thinking the heavily damaged Carmania was a trap, thus losing the chance to both save German sailors and to sink a dangerous opponent
 Brexit.
Brexit.
💯% This is what happens when a percentage of people decide they don't like 'foreigners' - and incentivised by a Govt telling everyone that the EU were ripping us off. We've suffered economically ever since. 72.2% of those old enough to vote, took part. 51.9% LEAVE, 48.1% voted REMAIN. It was too close a call, yet the Govt (PM David Cameron) still let it go through.
 300 Australians trapped in a coastal African city held off 1000s of Italians for months during WW2.
300 Australians trapped in a coastal African city held off 1000s of Italians for months during WW2.
They accomplished this by throwing Australian wildlife, which they had brought along for just such an occasion, at the enemy.
 The Native Americans being forced out of their homes.
The Native Americans being forced out of their homes.
 That pirate who had a bounty on him, so he put a bounty on the guy who put it on him, making it a real 'No u' moment.
That pirate who had a bounty on him, so he put a bounty on the guy who put it on him, making it a real 'No u' moment.
mclv7gaming:
Jean Lafitte for anyone interested.
 Thomas Fitzpatrick drunkenly stealing a plane on a bet.
Thomas Fitzpatrick drunkenly stealing a plane on a bet.
YoungXanto:
Twice!
The second time was better though because he was bragging about stealing a plane and landing it in the street in Manhattan and some other drunk was like, "bullsh**!".
Rather than argue with this man, he just went right ahead and did it again, right then and there.
Anyone insane enough to steal a plane and land it in Manhattan once is also insane enough to do it twice. And most certainly won't stand for having his word questioned by some drunk at a bar.
My brothers been doing better than ever, hes been out of prison for 1 year. In the last 20years hes never been out and stayed out more than 2 weeks. He likes jail. Hes good at it and hes popular there which is weird but its true. A few years ago, at a gas station, someonw had told my brother he wouldnt steal another car again (what hed just gotten out for) so he stole the cop car running outside of the store just so he felt like the top dog. The man was like 35 yrs old!
 The destruction of Khwarezmia by Genghis Khan.
The destruction of Khwarezmia by Genghis Khan.
Genghis Khan forged a peace treaty with the Shah of Khwarezmia. After the treaty was signed, the Khan sent a 500-man caravan to officially establish trade ties with the empire. However the governor of the Khwarezmian city of Otrar had the entire caravan arrested, claiming they were conspiring against the empire. The Khan then sent three ambassadors (one Muslim and two Mongols) to the Shah negotiate the release of the caravan. The Shah had the Mongol ambassadors shaved bald and the Muslim ambassador beheaded before sending them back to the Khan. This angered the Khan, who considered ambassadors to be "sacred and inviolable."
So he led the Mongols over the Tien Shan mountains and in less than two years the entire Khwarezmian civilization was completely wiped out. As each city in the empire was captured, the defenders were e**cuted, women and children given to Mongol soldiers as slaves, artisans captured and sent back to Mongolia as servants, and the cities sacked. When the city where the Shah had been born surrendered, the Mongols broke the dams on the nearby rivers, causing a flood that literally wiped the city off the map.
TL;DR, never break a peace treaty with Genghis Khan.
 Both nukes the US dropped on Japan but especially Nagasaki.
Both nukes the US dropped on Japan but especially Nagasaki.
anonymous:
There was a guy who was in Hiroshima for the first b**b and then took a train to work in Nagasaki just in time for the second one. And he survived.
 When the Scottish people thought to invade England when they were infected by the plague because they were weaker. Then taking it back to their own country, and giving everyone the plague there.
When the Scottish people thought to invade England when they were infected by the plague because they were weaker. Then taking it back to their own country, and giving everyone the plague there.
I do love when the photo has the usual disclaimer under it, such as this one does [TheRitualMaster,EyeEm/Freepik (not the actual photo)] because it's as if they want to make sure that we are not disappointed that there isn't an actual photograph showing people with the plague in 1348.
 The complete and total overk**l of Grigori Rasputin.
The complete and total overk**l of Grigori Rasputin.
anonymous:
Overk**l??? if they hadn't thrown him into the river rolled into a rug with his hands restrained (which he got out of (although thats just a theory)) after poisoning him with 5 times the poison to k**l a regular man (which he complained of an upset stomach) and then sh**ting him 4 times. I dont think it was too overkill. seemed to be just right for that legendary man.
🎵🎶Rah! Rah! Rasputin! Russia's Greatest Love Machine! They put some poison into his wine.🎶🎵
 The Winter War. Stalin was paranoid about a potential attack from the Northwest, so he decided to try and take the snowy nation of Finland, and suffered heavy casualties. Finland eventually signed a ceasefire and lost some territory, but the USSR lost roughly 300,000 men, compared to the Finn's 65,000.
The Winter War. Stalin was paranoid about a potential attack from the Northwest, so he decided to try and take the snowy nation of Finland, and suffered heavy casualties. Finland eventually signed a ceasefire and lost some territory, but the USSR lost roughly 300,000 men, compared to the Finn's 65,000.
 The War of the Bucket. There was a long standing tension between rival cities and eventually some thought it would be brilliant to steal a single oak bucket from the center of the city. When the city threatened war unless the bucket was returned, they laughed it off. This caused a war where hundreds d**d. The victors still have the bucket on display in their city.
The War of the Bucket. There was a long standing tension between rival cities and eventually some thought it would be brilliant to steal a single oak bucket from the center of the city. When the city threatened war unless the bucket was returned, they laughed it off. This caused a war where hundreds d**d. The victors still have the bucket on display in their city.
 When Ronald Reagan was giving a speech in Berlin and a very loud balloon popped. Everyone thought it was a gunshot and he had the nerve to say “you missed me”.
When Ronald Reagan was giving a speech in Berlin and a very loud balloon popped. Everyone thought it was a gunshot and he had the nerve to say “you missed me”.
 The Bubonic Plague was a magnitude 10 bruh moment.
The Bubonic Plague was a magnitude 10 bruh moment.
DankkaM:
"Let's go into one building to pray this horrible epidemic stops. And take your family too, because in a church theres always room for people to get infected"
 **This war is the last war of mankind it will end the other wars**
**This war is the last war of mankind it will end the other wars**
and then ww2 happened.
The War to end all wars just started the next big conflict, kinda ironic
 That one time that one army split up to flank the enemy army and ended up attacking itself.
That one time that one army split up to flank the enemy army and ended up attacking itself.
ppcsptr:
The battle of Karánsebes.
 Napoleon I coming back to conquer Europe after he already got defeated. Then he immediately got defeated again.
Napoleon I coming back to conquer Europe after he already got defeated. Then he immediately got defeated again.
Amusingly, the train from Paris to London was originally planned to stop at Waterloo. The French were not amused, apparently. That's why it goes to St Pancras.
 The sinking of the Titanic.
The sinking of the Titanic.
ph_uck_yu:
“This boat is unsinkable.” The irony of it sinking on its first trip out is both hilarious and devastating.
I think calling a ship unsinkable is bad luck, the Yamato certainly wasn't either
 President Garfield’s d**th.
President Garfield’s d**th.
He was shot in an assassination attempt. The bullet didn’t hit anything important and he would have lived if not for the infection he got from all the dirty fingers trying to dig the bullet out. I guess soap didn’t exist back then.
Soap existed. An understanding of the importance of Hygiene in medicine was in very short supply, however.
 When three dudes claimed to be pope and all got excommunicated.
When three dudes claimed to be pope and all got excommunicated.
The Western Schism (1378–1417). After the Papacy had a long stay in Avignone for political motives that is too long to explain here, Gregory XI moved back to Rome, despite he feared being killed by his enemies. To no one's surprise, he was pretty soon killed by his enemies. A new pope, Urban VI was elected in Rome, but he was quite a character and pissed off everybody within minutes. The conclave then claimed they got this wrong and elected a new one, Clement VII, who took seat back in Avignon. So, for about 50 years there were to separate lines: Roman Popes (4 in total) and Avignon Antipopes (two). Cardinals called a council in Pisa, and deposed both the popes, replacing them with the newly elected Alexander V, who had a mild case of sudden death and was replaced by John XXIII. The three excommunicated each other.
 Pompeii when Vesuvius became active. They had just fixed the earthquake damage on the buildings and were ready to get the plastering teams in. Worse day in the building industry ever.
Pompeii when Vesuvius became active. They had just fixed the earthquake damage on the buildings and were ready to get the plastering teams in. Worse day in the building industry ever.
Silly AI: showing us a Pink Floyd concert instead of a volcano. (ICYMI, just before Pink Floyd was marketed to America, they held a "concert" in the arena pictured. Even though there were no attendees, it was considered a masterful live performance and helped launch their mega-stardom.)
America during the War of 1812 invading Canada and ending up getting the white house burnt down.
Not burnt down. A rainstorm stopped there being significant damage. It became the White House after that incident because of the white paint used to cover the soot marks.
 When the nomadic Hungarian tribes arrived to Europe to settle down they had a meeting with the inhabitants of the land of present Hungary where they asked for a gourd of water, some grass and a pile of dirt in exchange of a beautiful white horse, a saddle and a golden reins.
When the nomadic Hungarian tribes arrived to Europe to settle down they had a meeting with the inhabitants of the land of present Hungary where they asked for a gourd of water, some grass and a pile of dirt in exchange of a beautiful white horse, a saddle and a golden reins.
The inhabitants accepted the trade and the next day the Hungarian armies proceeded to conquer the lands, because "they agreed to it" by accepting the exchange.
As you can easily guess, this is a legend and not an historical event. The original myth frame the trade of the horse as an exchange for "grass, water and soil", and is reported in one semi-mythical XII century chronicle (later picked up by a second but it's derivative), written three centuries later. Actual contemporary historiae and annals make no mention of the exchange, and recount the invasion as just a bunch of nomadic incursions later turned into occupation. There is a major anachronism in the original legend, that features king Svatopluk I of Moravia as the ruler who accepted the deal: He was already dead by about three decades by the time the Hungarian tribes showed up at the border for the first time.
 When whatshisface returned to Roanoke and found absolutely nothing but a word carved into a tree.
When whatshisface returned to Roanoke and found absolutely nothing but a word carved into a tree.
 There was a kingdom who recently got a new king who was about 17 years old (still a teenager). There was another empire they were fighting on another side of this massive rock. There were two ways to get around the rock: through (there was a ravine but you would get easily ambushed and slaughtered) or around the rock. The kings military advisor advised him to go around the rock because the enemy surely would be ready with arrows to ambush their army. The naive king ignored him and decided to go through the ravine. It turns out that the enemy thought that the king would go around the rock so they also went that way too and they both completely missed each other.
There was a kingdom who recently got a new king who was about 17 years old (still a teenager). There was another empire they were fighting on another side of this massive rock. There were two ways to get around the rock: through (there was a ravine but you would get easily ambushed and slaughtered) or around the rock. The kings military advisor advised him to go around the rock because the enemy surely would be ready with arrows to ambush their army. The naive king ignored him and decided to go through the ravine. It turns out that the enemy thought that the king would go around the rock so they also went that way too and they both completely missed each other.
EDIT: I am pretty sure that it was Thutmose III who was an Egyptian pharaoh in the battle of Megiddo.
 Archduke Franz Ferdinand survived an assassination attempt but, later that day, his driver took a wrong turn on their way to the hospital to visit wounded citizens from the attack. They drove past another assassin having a snack at an outdoor cafe. Needless to say he did a better job than the first guy. RIP Europe.
Archduke Franz Ferdinand survived an assassination attempt but, later that day, his driver took a wrong turn on their way to the hospital to visit wounded citizens from the attack. They drove past another assassin having a snack at an outdoor cafe. Needless to say he did a better job than the first guy. RIP Europe.
Edit: Bruh, some of the details are incorrect I.E they made it to the hospital and then we’re returning home, Princip wasn’t eating a sammich, etc. The gist remains the same.
Also, I am well aware WW1 would have occurred anyways but this assassination was the spark that lit the tinderbox.
The japanese attacking pearl harbor. The germans must've been like bruh.
No one twisted Germany's arm to force them to declare war on the US a day or two later.
 Italy changing teams in both world wars.
Italy changing teams in both world wars.
In WWI Italy didn't change sides: while it was part of the Triple Alliance (a defensive pact), nothing in the pact required them to take part in the war, and in fact the Austrians behaved in a way that breached the terms of the agreement. Italy remained neutral for the first year, then came in on the allied side. It didn't change sides.
Can't remember the name of the operation (EDIT : Starfish Prime, 1962), but that time the US decided to detonate one of their biggest nukes in the upper stratosphere to see what it would do to the Earth's magnetic field, without even considering just simulating it.
They almost tore the whole thing off the planet, and ended up adding a new magnetic layer to the field. They almost killed everything on Earth by doing stupid s**t with their nukes. Bruh.
The second part is unnecessarily overdramatic, the result was just a bunch of early satellites' electronics being fried. But yeah, "let's try and see" was pretty much the go-to experimental approach of US scientists in the 1950s and 1960s, especially the ones working on atomics. TBF, there was no way of "simulating" it, they were missing so many data that trying was the only way of getting some numbers for the boffins to try and make sense of the whole thing.
I'm surprised no ones said it but the Falklands war. It's so petty, the UK didn't even know of the invasion until "Argentine sources" told them of it and then it was essentially over as soon as the UK responded.
Well, we took a few days to get our boats over there, and one did get hit.
When Alexander Hamilton said to Thomas Jefferson
# "There are approximately 1,010,300 words in the English language and I could not string together a sentence to explain how much I want to hit you with a chair.".
It's easy, look: "Bruh. You need a high five. In the face. With a chair."
The Anglo-Zulu War of 1879 produced two major “bruh moments.”
The Battle of Isandlwana first: the British enter Zululand with the same arrogance and sureness of their imperial superiority they were renowned for. They camp under the rock formation at Isandlwana. The Zulus light a fire some distance away, and Lord Chelmsford, the commander, takes half of his force to investigate. While he’s gone, two patrols go up a mountain and see an army of 10,000 Zulus hiding behind it. They panic, and fire at them. The Zulus let out a cry of “USUTHU!” and storm the camp using their “Horns of the Buffalo” tactic. The British are decisively defeated.
All of this under a rare Blood Moon.
The very next day, one of the “horns” of the buffalo make their way to the field hospital at Rorke’s Drift. They attack. But the British soldiers guarding the place put up a tough resistance. Less than 150 soldiers manage to repel an attack of 4000 Zulu troops - most of it in Close Quarters Combat, where the Zulus have an advantage due to their shields, clubs and assegai spears, with a loss of 17 British and 351 Zulu.
By the end of the battle, the Zulus were singing a song and dance to salute their opponents for their well-fought battle.
Constantinople fell because a group of byzantine soldiers accidentally left a small door called the kerkoporta open, which allowed a group of 50 ottoman soldiers to gain entry into the city and raise their flag, that caused mass panic in the defenders and made them retreat. All of this subsequently led to the fall of the city and with it, the Byzantine Empire.
Another story that is far more legend than history. Originated from a single source, the Doukas Memories (1460 circa); Doukas was not an eyewitness and his retelling often include moralizing stories and religious parables in the Byzantine tradition. Neither of the historical sources, including Nicolò Barbaro (a Venetian historian that was in the city, took part in the siege defense and led a daring escape) and Leonardo Giustiniani (a Dominican who acted as Papal delegate in the city, was captured and wrote a detailed report to the Pope), make mention of this "kerkoporta". Historians reported how the city fell from the pressure of weeks of constant bombardment, with a few thousand remaining defenders against 10 to 15 times as much besiegers, in a city without any supplies left; they write about how the city fell after a whole day of ferocious fighting that claimed the life of the emperor himself fighting in the battle inside the walls.
The Great Depression.
When Columbus found out he had discovered native Americans, not "Indians", after calling them that for a while.
He never found out. By the time he died, he was pretty sure they were not Indians-from-india but he was still trying to figure out which specific tribe of Asians he met. His letters from the last voyage go into this, and show he already realized that culture, language, and geography did not match known descriptions of Asiatic populations, but he was still convinced he arrived SOMEWHERE in Asia. There is a single letter in his Fourth Voyage stating that "I have come to the conclusion that these lands are not part of the Indies, but may be new lands unknown to the world", but is later glossed over in following public writings.
Thermopylae, according to the Persians.
There was a young man from Thermopylae / Who never did anything properly
 The Boston Tea Party was a huge bruh moment.
The Boston Tea Party was a huge bruh moment.
Especially when they started to sweep the decks of the boats after yeeting the tea overboard, certified bruh moment.
 Wright Brothers: Hmm, these flying machines could be a hit, let's learn more about em.
Wright Brothers: Hmm, these flying machines could be a hit, let's learn more about em.
Gustave Whitehead: Sup dudes, what do you think of my sweet as plane?
WB: Hot d**n son, it's cool as hell. Give us a look at them schematics.
GW: Sure, I'm super pumped when people are interested in this stuff.
*four years later*
WB: Check it out world, we flew first! In this plane we invented.
GW: BRRRRUH, not cool, you know I did this first.
WB: Oh hey GW, if you wanna keep making planes, I mean uh *start* making planes you better pay up, cuz we own the patent.
GW: *BRUH INTENSIFIES*.
Even taking Whitehead claims at face value, Clément Ader did the same a decade before. In both cases, while they flew for a few meters, they had no means to control the direction. The Wright Flyer hold the distinction for the first 1) Manned 2) heavier than air 3) powered and 4) CONTROLLED aircraft. Manned has been dealt with since the Montgolfier brothers (1783). Heavier than air was 1853 with George Cayley's gliders. Powered was Adler in 1890. The big deal was everything being controlled.
"Los últimos de Filipinas"; Soldiers besieged in a small catholic mission during the war between Spain and Philippines (and later USA too), being told the war is over and to get the f**k out, they thought it was a trap to make them leave the fortified positions, and stood their ground besieged in there for over a year after the war officially ended.
When the King George II, after issuing coins commemorating the sure victory of Admiral Vernon with 250 ships and 25.000+ men against the Spanish defenders of Cartagena de Indias with 6 ships and 3.400 men (600 of those native archers), got the news that Vernon had, in fact, lost.
When the Mongols tried to invade Japan but d**d in a tornado, after they tried to invade Japan but d**d in a tornado.
 When Khosrau I of the Sassanid Empire literally built an exact, better version of Antioch just to show off to the Byzantines.
When Khosrau I of the Sassanid Empire literally built an exact, better version of Antioch just to show off to the Byzantines.
1. Assassination attempt on Andrew Jackson where assassin tried to sh**t Jackson from close quarters, but the powder didn’t light, so he grabbed a second gun, and it didn’t fire so Jackson took his cane and started beating the man.
2. The term “getting the ball rolling” came from William Henry Harrison’s campaign. After which, he won (mainly because he was the only candidate who didn’t say anything about slavery) and he gave the longest inaugural speech in us history without a coat... in dc... in the rain. Ended up catching some disease and died like a month into his term, leaving John Tyler as president who did practically nothing to reduce tensions between the north and south.
3. Sumner Brooks affair.
#2. So the story told at the time went. Modern historians think his symptoms were much closer to typhoid fever. Washington had no sewage system at the time, and many in the White House got sick that year from drinking contaminated water. But the speech theory makes for a better story. Also the phrase "get the ball rolling" is connected to Harrison's campaign, but it was already a popular phrase, and had nothing to do with his death. The phrase came out of 18th century sports columns in news papers. Harrison ran in 1840. His campaign chanted the phrase "keep the balls rolling" as a metaphor for continued American success.
The e*******n of Topsy the elephant. In 1903 Topsy the elephant was fed cyanide, and then electrocuted and simultaneously hung. The whole spectacle was filmed for Edison's campaign against AC.
anonymous:
Edison's involvement is actually an urban myth. The electrocution took place a decade after the so called "War of Currents" and Edison had almost nothing to do with it.
The event was filmed by a company that he owned, and the film was sold via penny viewer, but wikipedia makes it sound like it was an opportunistic filming, rather than set up by them.
When the chicxulub impact happened.
The Chicxulub crater, located on the Yucatán Peninsula in Mexico, is a significant impact site formed by a massive asteroid collision approximately 66 million years ago, which is widely believed to have contributed to the mass extinction of the dinosaurs.
2012 - the end of the world...... Didn't happen. I'm still alive.
Bruhhhh.
One of these days I'd like to make a list of apocalypses that didn't happen. Starting with the prediction that the opening of the Suez canal would destroy all Mediterranean countries.
The Challenger explosion.
100% preventable. Engineers who knew it was a danger warned the higher ups, but the bean counters did not want to spend the money to delay the launch again. Then things like that never happened again after than (*coughcough* Oceansgate *couchcouch*)
The German-Soviet Nonaggression Pact being broken.
There is a lot of background to it, and -as usual- the blame is squarely on the British. Stalin had repeatedly reached out to western powers offering mutual assistance. He was ignored because at the time Communism was a touchy subject on the west, with workers' revolts going on and vocal communist parties popping up right left and center: most western governments took a "no contact" policy, deciding to cut any diplomatic activity with Russia. When Litvinov and Molotov on Stalin's orders came knocking on Britain's and France's consulate doors they were met with stalling, distrust and an endless slew of meetings with officers without any decision power. Stalin terms were unexpectedly reasonable: Mutual assistance against Germany, guarantees of independence for Poland, Romania and Baltic States (well, he had a plan to snatch them later on but...). Britain and France at some point sent to an agreed meeting to sign the deal the umpteenth diplomat who had no signing powers, Stalin snapped.
 Troy.
Troy.
Accepting a giant wood horse as a gift, and then having your city taken over by soldiers in the horse.
I need not say more.
Not again... It's a mistranslation. There was no "wood horse". The "Hyppus" was a type of greek/phoenician cargo ship. The retreating army left, leaving all the unnecessary equipment on the shore. The Troians pillaged these stuff (remember the US troops leaving afghanistan, same thing). Soldiers were hidden in the large boat, came out at night and attacked the city while celebrations were ongoing.
Romulus k**ling Remus for the naming rights of Rome.
Maggie Thatcher going on national TV to say categorically that the UK will not employ atomic weapons against Argentina, as our 1 week from retirement Nuclear bomber which just flew 3000 miles across the Atlantic nailed the Port Stanley airfield.
When Italians fought the ancient Romans for citizenship, and lost, then being granted citizenship in the aftermath.
Would have to be the invention of the first antibiotic.
Would have to be the invention of the first antibiotic.
And parting the red sea..you could just hear the pause and then someone deep in the crowd going.."Bruh....".
The real "bruh" moment of the invention of penicillin was Mary finding a cantaloupe in the local markets that was full of penicillin. All commercial penicillin is descended from her find.
Probably that time in WW1 where a French general used classical conditioning to trick a bunch of German soldiers into wearing gas masks when there was no gas and instead a full French a*****t.
A tiny little country from Europe colonized some pretty big countries of the modern world. That was the bruh moment for me.
 World War I. Literally fought over petty s**t and accomplished nothing. Oh, and pissed Germany off enough to start another war 21 years later.
World War I. Literally fought over petty s**t and accomplished nothing. Oh, and pissed Germany off enough to start another war 21 years later.
Alexander the Great, one of the single-most powerful generals of the ancient era who conquered d**n near the entire Middle East, being taken out by some random disease.
Also when in WW2 Germany was stuck in Russia because of the winter, but because the Russians were experts of the cold, they retaliated and kicked the Germans out of Russia.
Idk what people's beliefs are but the story of Adam and Eve, whether it's real or not. I mean I know it's not a historical event but these two people had one f*****g job and they both messed it up. Like wtf.
It's important to remember that the bible was written by mortal men about their version of God, not written by God for men.
When the british backup arrived before the french and they stood there for like 5 hours rubbing it in their faces.
Half of the country when Hillary Clinton didn’t get elected president. My favorite bruh moment of all history.
I was a bit stunned that Hillary was the best they could put up. Then Joe. Then Kamala. *facepalm*
OK. So I just read all the way through this list, but I still do not know what exactly is meant by a "bruh moment". Too old, I guess. Or is it not just an age thing?
Could be an age thing. I thought it made everything sound juvenile. And get off my lawn!
Load More Replies...Canada, reputation for being some of the nicest people in the world, is one of the main reasons the Geneva Convention exists.
Does anybody ever fact check these before posting them or is the job of a BP employee pressing CTRL-C / CTRL-V ?
Funny how I cringe reading some of BP responses in other BP articles meant to create division, however, in these type articles, I find myself admiring some of the knowledge present on BP. Weird, the dichotomy of that eh?
OK. So I just read all the way through this list, but I still do not know what exactly is meant by a "bruh moment". Too old, I guess. Or is it not just an age thing?
Could be an age thing. I thought it made everything sound juvenile. And get off my lawn!
Load More Replies...Canada, reputation for being some of the nicest people in the world, is one of the main reasons the Geneva Convention exists.
Does anybody ever fact check these before posting them or is the job of a BP employee pressing CTRL-C / CTRL-V ?
Funny how I cringe reading some of BP responses in other BP articles meant to create division, however, in these type articles, I find myself admiring some of the knowledge present on BP. Weird, the dichotomy of that eh?

 Dark Mode
Dark Mode 

 No fees, cancel anytime
No fees, cancel anytime 




































































